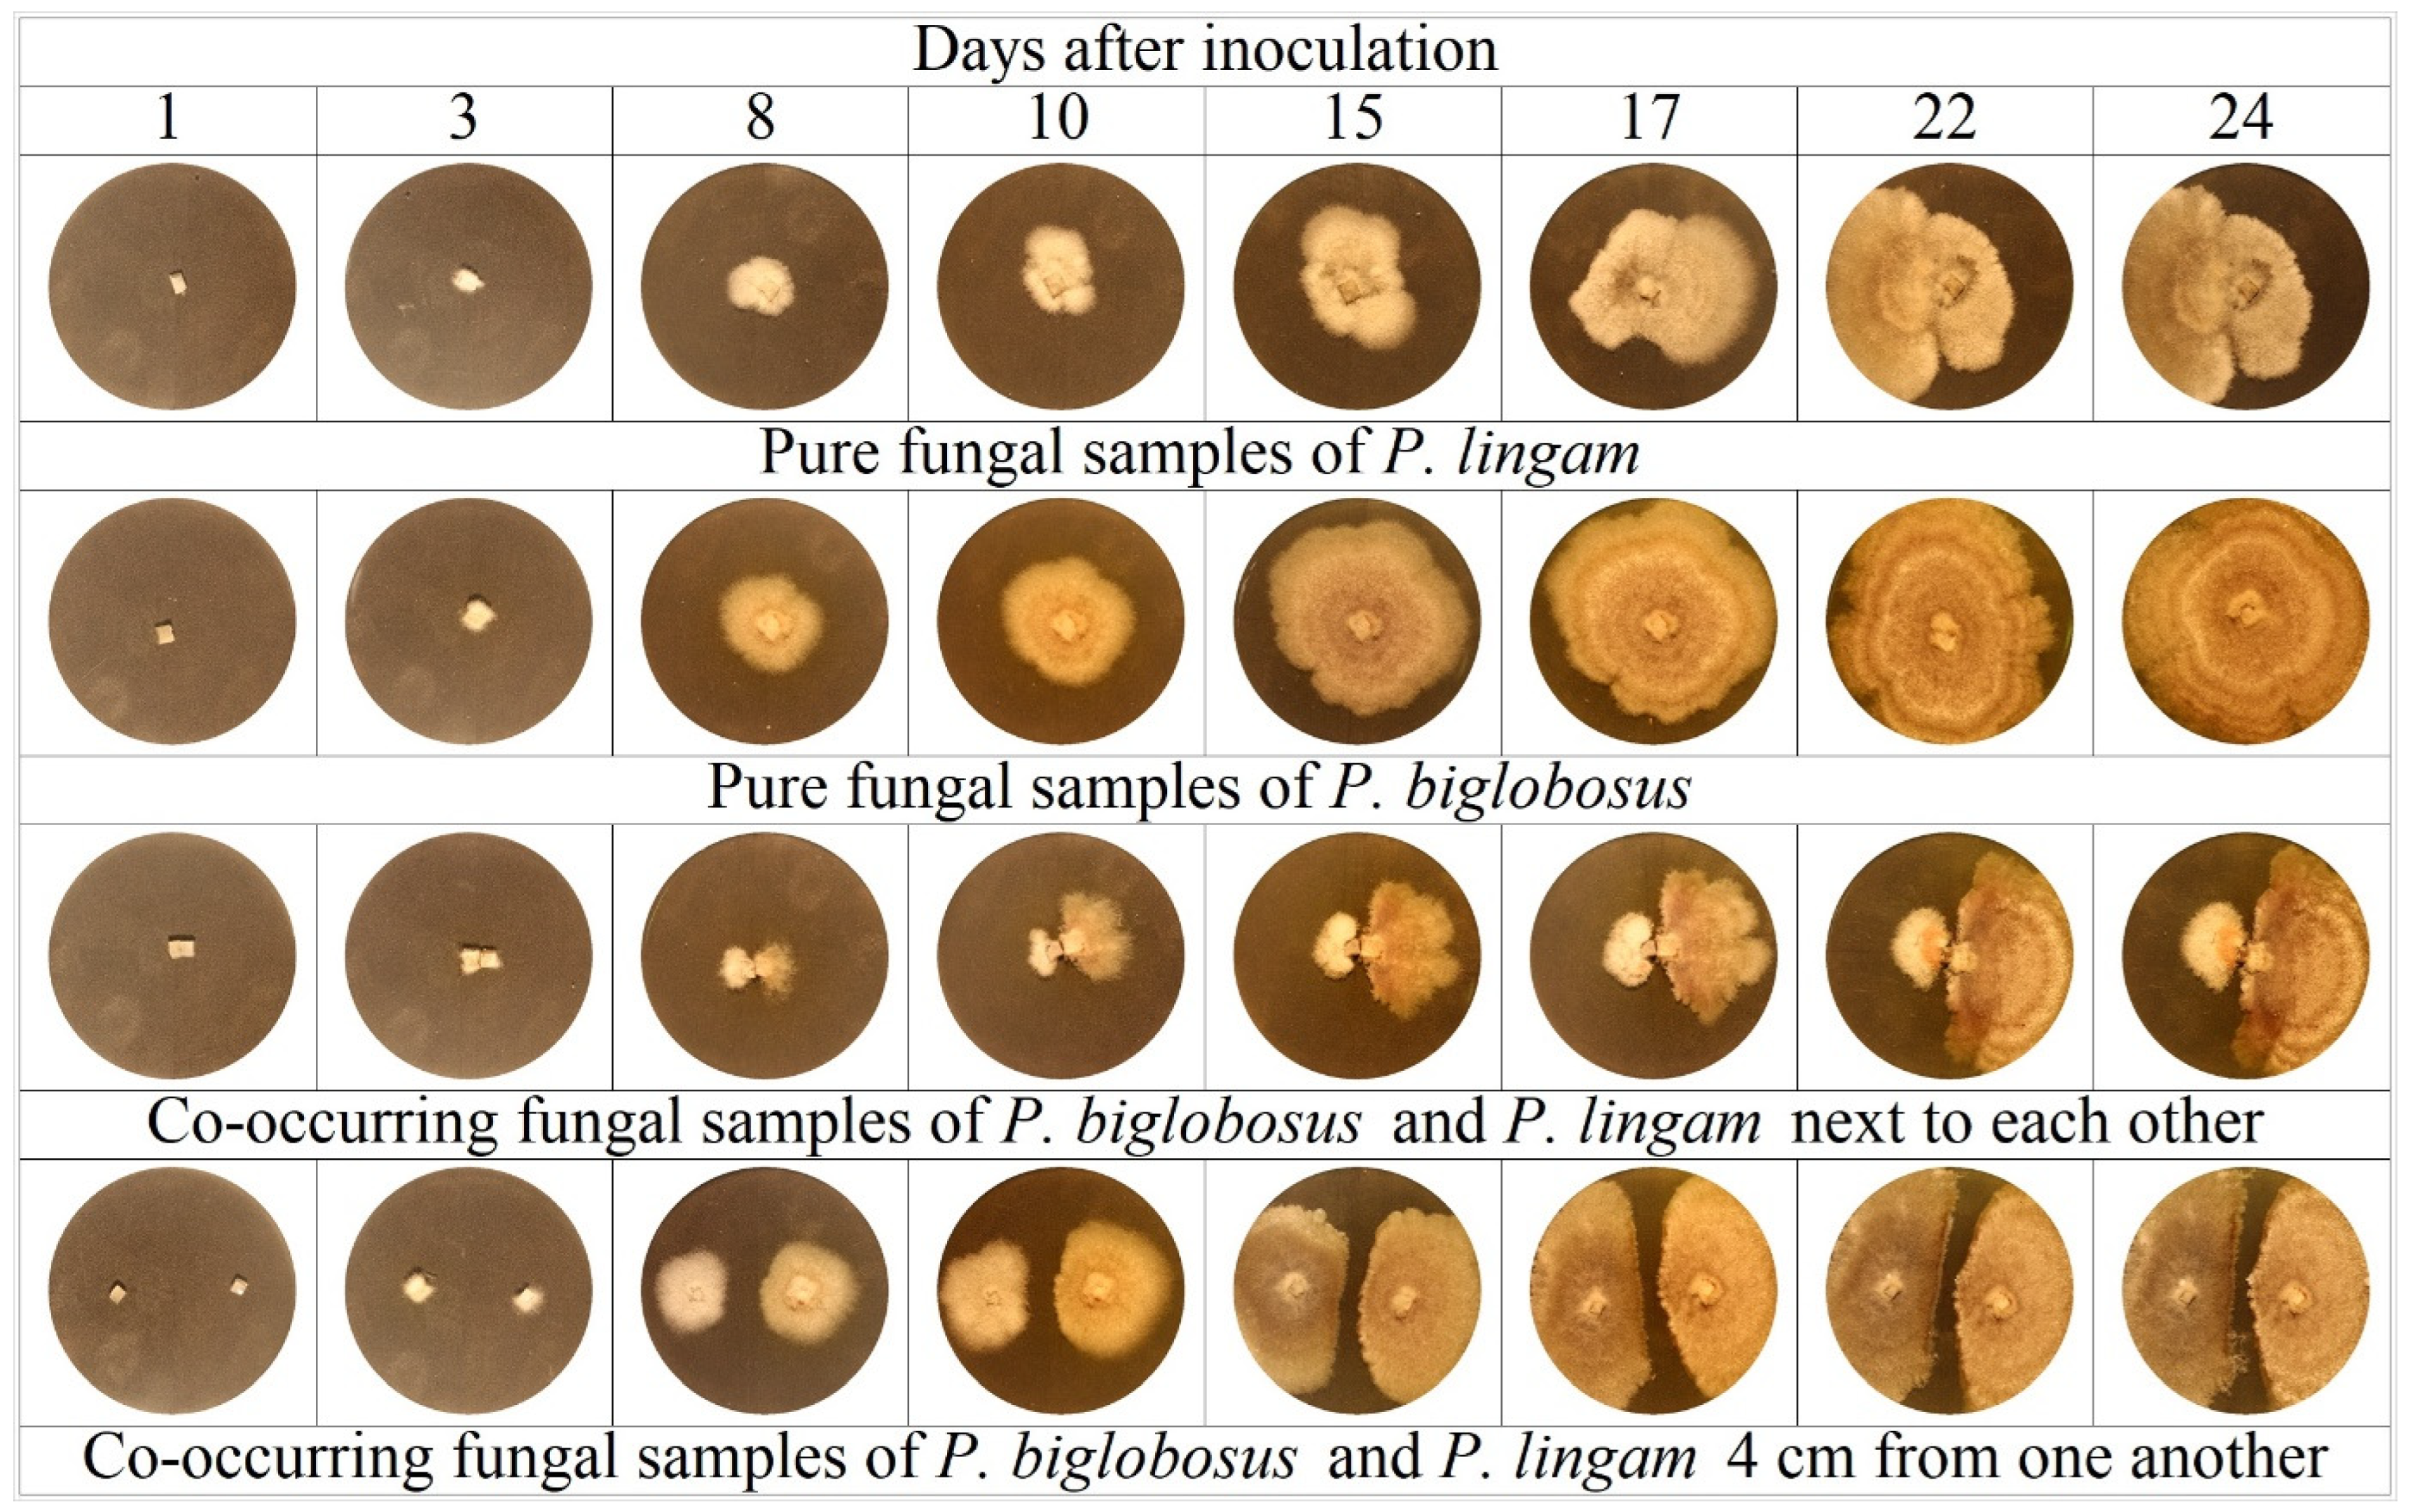
Agriculture 13 02228 g002

Classification of Plenodomus lingam and Plenodomus biglobosus in Co-Occurring Samples Using Reflectance Spectroscopy
Abstract
1. Introduction
2. Materials and Methods
2.1. Mycelial Growth
2.2. Measurement of Mycelial Areas
2.3. Spectral Measurements
2.4. Statistical Analysis
2.4.1. Qualitative Differentiation of Pure (PFS) and Co-Occurring (CoFS) Fungal Samples
2.4.2. Quantitative Assessment of Species in Co-Occurring Fungal Samples (Unmixing)
3. Results
3.1. Changes in Mycelial Areas
3.2. Temporal Changes in Mycelial Spectral Characteristics
3.3. Spectral Classification of Fungal Mycelia
3.4. Spectral Unmixing of Fungal Mycelia
4. Conclusions
Author Contributions
Funding
Institutional Review Board Statement
Informed Consent Statement
Data Availability Statement
Conflicts of Interest
References
- Yu, H.; Cheng, X.; Chen, C.; Heidari, A.A.; Liu, J.; Cai, Z.; Chen, H. Apple leaf disease recognition method with improved residual network. Multimed. Tools. Appl. 2022, 81, 7759–7782. [Google Scholar] [CrossRef]
- Camino, C.; Araño, K.; Berni, J.A.; Dierkes, H.; Trapero-Casas, J.L.; León-Ropero, G.; Montes-Borrego, M.; Roman-Écija, M.; Velasco-Amo, M.P.; Landa, B.B.; et al. Detecting Xylella fastidiosa in a machine learning framework using Vcmax and leaf biochemistry quantified with airborne hyperspectral imagery. Remote Sens. Environ. 2022, 282, 113281. [Google Scholar] [CrossRef]
- Moskovsky, M.N.; Shogenov, Y.H.; Lavrov, A.V.; Gulyaev, A.A.; Efremenkov, I.Y.; Pyatchenkov, D.S.; Belyakov, M.V. Spectral Photoluminescent Parameters of Barley Seeds (Hordéum vulgare) Infected with Fusarium ssp. Photochem Photobiol. 2023, 99, 29–34. [Google Scholar] [CrossRef] [PubMed]
- Martinelli, F.; Scalenghe, R.; Davino, S.; Panno, S.; Scuderi, G.; Ruisi, P.; Villa, P.; Stroppiana, D.; Boschetti, M.; Goulart, L.; et al. Advanced methods of plant disease detection. A review. Agron. Sustain. Dev. 2014, 35, 1–25. [Google Scholar] [CrossRef]
- Gorretta, N.; Nouri, M.; Herrero, A.; Gowen, A.; Roger, J.-M. Early detection of the fungal disease “apple scab” using SWIR hyperspectral imaging. In Proceedings of the 2019 10th Workshop on Hyperspectral Imaging and Signal Processing: Evolution in Remote Sensing (WHISPERS), Amsterdam, The Netherlands, 24–26 September 2019; pp. 1–4. [Google Scholar]
- He, L.; Qi, S.-L.; Duan, J.-Z.; Guo, T.-C.; Feng, W.; He, D.-X. Monitoring of Wheat Powdery Mildew Disease Severity Using Multiangle Hyperspectral Remote Sensing. IEEE Trans. Geosci. Remote Sens. 2021, 59, 979–990. [Google Scholar] [CrossRef]
- Francesconi, S. High-throughput and point-of-care detection of wheat fungal diseases: Potentialities of molecular and phenomics techniques toward in-field applicability. Front. Agron. 2022, 4, 980083. [Google Scholar] [CrossRef]
- Kasalica, B.V.; Miletic, K.M.; Sabovljevic, A.D.; Vujicic, M.M.; Jeremic, D.A.; Belca, I.D.; Petkovic-Benazzouz, M.M. Nondestructive optical method for plant overall health evaluation. Acta Agric. Scand. B Soil Plant Sci. 2021, 71, 1017–1023. [Google Scholar] [CrossRef]
- Calderón Madrid, R.; Navas Cortés, J.A.; Lucena León, C.; Zarco-Tejada, P.J. High-resolution hyperspectral and thermal imagery acquired from UAV platforms for early detection of Verticillium wilt using fluorescence, temperature and narrow-band indices. In Proceedings of the Workshop on UAV-Basaed Remote Sensing Methods for Monitoring Vegetation, Cologne, Germany, 11–12 September 2013; pp. 7–14. [Google Scholar]
- Oerke, E.C.; Leucker, M.; Steiner, U. Sensory assessment of Cercospora beticola sporulation for phenotyping the partial disease resistance of sugar beet genotypes. Plant Methods 2019, 15, 133. [Google Scholar] [CrossRef]
- Guo, A.; Huang, W.; Ye, H.; Dong, Y.; Ma, H.; Ren, Y.; Ruan, C. Identification of wheat yellow rust using spectral and texture features of hyperspectral images. Remote Sens. 2020, 12, 1419. [Google Scholar] [CrossRef]
- Chen, N.; Liu, F.; Jiang, L.; Feng, L.; He, Y.; Bao, Y. Diagnosis of Sclerotinia Infected Oilseed Rape (Brassica napus L) Using Hyperspectral Imaging and Chemomtrics. 2022. Available online: https://www.ispag.org/proceedings/ (accessed on 27 October 2023).
- Pereira, F.V.; Martins, G.D.; Vieira, B.S.; de Assis, G.A.; Orlando, V.S.W. Multispectral images for monitoring the physiological parameters of coffee plants under different treatments against nematodes. Precis. Agric. 2022, 23, 2312–2344. [Google Scholar] [CrossRef]
- Cubero, S.; Marco-Noales, E.; Aleixos, N.; Barbé, S.; Blasco, J. Robhortic: A field robot to detect pests and diseases in horticultural crops by proximal sensing. Agriculture 2020, 10, 276. [Google Scholar] [CrossRef]
- Osuna-Caballero, S.; Olivoto, T.; Jiménez-Vaquero, M.A.; Rubiales, D.; Rispail, N. RGB image-based method for phenotyping rust disease progress in pea leaves using R. Plant Methods 2023, 19, 86. [Google Scholar] [CrossRef]
- Pavicic, M.; Overmyer, K.; Rehman, A.U.; Jones, P.; Jacobson, D.; Himanen, K. Image-based methods to score fungal pathogen symptom progression and severity in excised Arabidopsis leaves. Plants 2021, 10, 158. [Google Scholar] [CrossRef] [PubMed]
- Long, T.; Ziyi, W.; Bowen, X.; Dong, L.; Hengbiao, Z.; Xia, Y.; Yan, Z.; Weixing, C.; Tao, C. A disease-specific spectral index tracks Magnaporthe oryzae infection in paddy rice from ground to space. Remote Sens. Environ. 2023, 285, 113384. [Google Scholar]
- Croeser, L. The Role of Phytophthora in Predisposing Corymbia Calophylla (marri) to a Canker Disease. Ph.D. Thesis, Murdoch University, Perth, Australia, 2021. [Google Scholar]
- Piekarczyk, J.; Ratajkiewicz, H.; Jasiewicz, J.; Sosnowska, D.; Wójtowicz, A. An application of reflectance spectroscopy to differentiate of entomopathogenic fungi species. J. Photochem. Photobiol. B Biol. 2019, 190, 32–41. [Google Scholar] [CrossRef] [PubMed]
- Aboelghar, M.; Wahab, H.A. Spectral footprint of Botrytis cinerea, a novel way for fungal characterization. Adv. Biosci. Biotechnol. 2013, 4, 374–382. [Google Scholar] [CrossRef][Green Version]
- Piekarczyk, J.; Wójtowicz, A.; Wójtowicz, M.; Jasiewicz, J.; Sadowska, K.; Łukaszewska-Skrzypniak, N.; Świerczyńska, I.; Pieczul, K. Machine Learning-Based Hyperspectral and RGB Discrimination of Three Polyphagous Fungi Species Grown on Culture Media. Agronomy 2022, 12, 1965. [Google Scholar] [CrossRef]
- Aboelghar, M.; Moustafa, M.S.; Ali, A.M.; Wahab, H.A. Hyperspectral analysis of Botrytis cinerea infected lettuce. EPH-Int. J. Agric. Environ. Res. 2019, 5, 26–42. [Google Scholar]
- Shoemaker, R.A.; Brun, H. The teleomorph of the weakly aggressive segregate of Leptosphaeria maculans. Canad. J. Bot. 2001, 79, 412–419. [Google Scholar] [CrossRef]
- Fitt, B.D.L.; Huang, Y.J.; van den Bosch, F.; West, J.S. Coexistence of related pathogen species on arable crops in space and time. Annu. Rev. Phytopathol. 2006, 44, 163–182. [Google Scholar] [CrossRef]
- Gaetan, S.A. First outbreak of blackleg caused by Phoma lingam in commercial canola fields in Argentina. Plant Dis. 2005, 89, 435. [Google Scholar] [CrossRef] [PubMed]
- Fitt, B.D.L.; Brun, H.; Barbetti, M.J.; Rimmer, S.R. World-wide importance of phoma stem canker (Leptosphaeria maculans and L. biglobosa) on oilseed rape (Brassica napus). Eur. J. Plant Pathol. 2006, 114, 3–15. [Google Scholar] [CrossRef]
- West, J.S.; Kharbanda, P.D.; Barbetti, M.J.; Fitt, B.D.L. Epidemiology and management of Leptosphaeria maculans (phoma stem canker) on oilseed rape in Australia, Canada and Europe. Plant Pathol. 2001, 50, 10–27. [Google Scholar] [CrossRef]
- Kuswinanti, T.; Koopmann, B.; Hoppe, H.H. Virulence pattern of aggressive isolates of Leptosphaeria maculans on an extended set of Brassica differentials. J. Plant Dis. Prot. 1999, 106, 12–20. [Google Scholar]
- Kuusk, A.K.; Happstadius, I.; Zhou, L.; Steventon, L.A.; Giese, H.; Dixelius, C. Presence of Leptosphaeria maculans group A and group B isolates in Sweden. J. Phytopathol. 2002, 150, 349–356. [Google Scholar] [CrossRef]
- Bagi, B.; Nagy, C.; Tóth, A.; Palkovics, L.; Petróczy, M. Plenodomus biglobosus on oilseed rape in Hungary. Phytopathol. Mediterr. 2020, 59, 345–351. [Google Scholar]
- Mazáková, J.; Urban, J.; Zouhar, M.; Rysanek, P. Analysis of Leptosphaeria species complex causing phoma leaf spot and stem canker of winter oilseed rape (Brassica napus) in the Czech Republic. Crop. Pasture Sci. 2017, 68, 254–264. [Google Scholar] [CrossRef]
- Brazauskiene, I.; Piliponyte, A.; Petraitiene, E.; Brazauskas, G. Diversity of Leptosphaeria aculans/L. biglobosa species complex and epidemiology of phoma stem cancer on oilseed rape in Lithuania. Plant Pathol. J. 2011, 93, 577–585. [Google Scholar]
- Gil-Lamaignere, C.; Roilides, E.; Hacker, J.; Müller, F.-M.C. Molecular typing for fungi—A critical review of the possibilities and limitations of currently and future methods. Clin. Microbiol. Infect. 2003, 9, 172–185. [Google Scholar] [CrossRef]
- Huleihel, M.; Shufan, E.; Tsror, L.; Sharaha, U.; Lapidot, I.; Mordechai, S.; Salman, A. Differentiation of mixed soil-borne fungi in the genus level using infrared spectroscopy and multivariate analysis. J. Photochem. Photobiol. B Biol. 2018, 180, 155–165. [Google Scholar] [CrossRef]
- Salman, A.; Shufan, E.; Lapidot, I.; Tsror, L.; Mordechai, S.; Sharaha, U.; Huleihel, M. Infrared spectroscopy and multivariate analysis: Classification of mixed fusarium species solani and oxysporum isolates at the species level. In Proceedings of the 2016 IEEE International Conference on the Science of Electrical Engineering (ICSEE), Eilat, Israel, 16–18 November 2016; pp. 1–5. [Google Scholar]
- Xian, W.; Božič, A.; Snavely, N.; Lassner, C. Neural Lens Modeling. In Proceedings of the IEEE/CVF Conference on Computer Vision and Pattern Recognition, Vancouver, BC, Canada, 17–24 June 2023; pp. 8435–8445. [Google Scholar] [CrossRef]
- Mueller, D.S.; Dorrance, A.E.; Derksen, R.C.; Ozkan, E.; Kurle, J.E.; Grau, C.R.; Gaska, J.M.; Hartman, G.L.; Bradley, C.A.; Pedersen, W.L. Efficacy of fungicides on Sclerotinia sclerotiorum and their potential for control of Sclerotinia stem rot on soybean. Plant Dis. 2002, 86, 26–31. [Google Scholar] [CrossRef] [PubMed]
- Sivakumar, D.; Wijeratnam, W.R.S.; Wijesundera, R.L.C.; Marikar, F.M.T.; Abeyesekere, M. Antagonistic effect of Trichoderma harzianum on post-harvest pathogens of Rambutan (Naphelium lappaceum). Phytoparasitica 2000, 28, 240–247. [Google Scholar] [CrossRef]
- Gabriel, K.R. The biplot graphic display of matrices with application to principal component analysis. Biometrika 1971, 58, 453–467. [Google Scholar] [CrossRef]
- Breiman, L. Random Forests. Mach. Learn. 2001, 45, 5–32. [Google Scholar] [CrossRef]
- Chen, T.; Guestrin, C. Xgboost: A scalable tree boosting system. In Proceedings of the 22nd ACM Sigkdd International Conference on Knowledge Discovery and Data Mining, San Francisco, CA, USA, 13–17 August 2016; pp. 785–794. [Google Scholar]
- Zou, H.; Hastie, T. Regularization and variable selection via the elastic net. J. R. Stat. Soc. Ser. B Stat. Methodol. 2005, 67, 301–320. [Google Scholar] [CrossRef]
- Fix, E.; Hodges, J.L., Jr. Discriminatory Analysis—Nonparametric Discrimination: Small Sample Performance; University of California: Berkeley, CA, USA, 1952. [Google Scholar]
- Ludwig, B.; Murugan, R.; Parama, V.R.; Vohland, M. Use of different chemometric approaches for an estimation of soil properties at field scale with near infrared spectroscopy. J. Plant Nutr. Soil Sci. 2018, 181, 704–713. [Google Scholar] [CrossRef]
- Helland, I.S. PLS regression and statistical models. Scand. J. Stat. 1990, 17, 97–114. [Google Scholar]
- Newbery, F.; Ritchie, F.; Gladders, P.; Fitt, B.D.L.; Shaw, M.W. Inter-individual genetic variation in the temperature response of Leptosphaeria species pathogenic on oilseed rape. Plant Pathol. 2020, 69, 1469–1481. [Google Scholar] [CrossRef]
- Jędryczka, M. Epidemiologia i szkodliwość suchej zgnilizny kapustnych na rzepaku ozimym w Polsce. Rozpr. I Monogr. IGR PAN. 2006, 17, 1–150. (In Polish) [Google Scholar]
- McGee, D.; Petrie, G. Variability of Leptosphaeria maculans in relation to blackleg of oilseed rape. Phytopathology 1978, 68, 625–630. [Google Scholar] [CrossRef]
- Williams, R.H.; Fitt, B.D.L. Differentiating A and B groups of Leptosphaeria maculans, causal agent of stem canker (blackleg) of oilseed rape. Plant Pathol. 1999, 48, 161–175. [Google Scholar] [CrossRef]
- Chu, X.; Chen, J.; Tang, Y.; Gao, S.; Zhuang, J.; Luo, S. Evaluating Growth of Colletotrichum species by Near infrared (NIR) hyperspectral imaging. IFAC-Pap. 2019, 52, 257–262. [Google Scholar] [CrossRef]

| Number | Experimental Combination | Pure/Co-Occurring Samples |
|---|---|---|
| 1 | P. lingam | Pure fungal samples |
| 2 | P. biglobosus | Pure fungal samples |
| 3 | P. lingam and P. biglobosus together on the same plate next to each other | Co-occurring fungal samples |
| 4 | P. lingam and P. biglobosus together on the same plate at a distance of 4 cm from one another | Co-occurring fungal samples |
| Days after Inoculation | Pure Fungal Samples (PFSs) | Co-Occurring Fungal Samples (CoFSs) | |||||||
|---|---|---|---|---|---|---|---|---|---|
| 1st Comb. | 2nd Comb. | 3rd Comb. | 4th Comb. | ||||||
| P. ling. | P. biglo. | Ratio P. biglo./P. ling. | P. ling. | P. biglo. | Ratio P. biglo./P. ling. | P. ling. | P. biglo. | Ratio P. biglo./P. ling. | |
| 1 | 0.3 | 0.3 | 0.9 | 0.3 | 0.2 | 0.9 | 0.2 | 0.2 | 1.0 |
| 3 | 1.9 | 2.3 | 1.2 | 1.9 | 1.2 | 0.6 | 2.0 | 1.7 | 0.9 |
| 8 | 24.3 | 46.8 | 1.9 | 7.8 | 15.5 | 2.0 | 42.0 | 50.6 | 1.2 |
| 10 | 45.0 | 90.4 | 2.0 | 10.9 | 29.8 | 2.7 | 79.9 | 94.1 | 1.2 |
| 15 | 143.6 | 303.3 | 2.1 | 27.6 | 102.0 | 3.7 | 217.2 | 258.6 | 1.2 |
| 17 | 205.6 | 430.2 | 2.1 | 38.4 | 149.4 | 3.9 | 279.2 | 342.5 | 1.2 |
| 22 | 423.6 | 814.7 | 1.9 | 77.6 | 307.7 | 4.0 | 437.3 | 560.9 | 1.3 |
| 24 | 529.2 | 988.0 | 1.9 | 98.7 | 384.7 | 3.9 | 505.7 | 649.2 | 1.3 |
| Days after Inoculation | PLSR | XGB | RF | EN | KNN |
|---|---|---|---|---|---|
| 1 | 1.234 | 0.676 | 0.687 | 0.67 | 0.769 |
| 3 | 1.891 | 1.651 | 1.656 | 1.823 | 1.634 |
| 8 | 1.014 | 0.55 | 0.525 | 0.495 | 0.707 |
| 10 | 0.973 | 0.707 | 0.718 | 0.514 | 0.561 |
| 15 | 0.509 | 0.321 | 0.357 | 0.368 | 0.463 |
| 17 | 0.502 | 0.279 | 0.318 | 0.323 | 0.392 |
| 22 | 0.174 | 0.257 | 0.256 | 0.339 | 0.343 |
| 24 | 0.199 | 0.27 | 0.26 | 0.378 | 0.25 |
Disclaimer/Publisher’s Note: The statements, opinions and data contained in all publications are solely those of the individual author(s) and contributor(s) and not of MDPI and/or the editor(s). MDPI and/or the editor(s) disclaim responsibility for any injury to people or property resulting from any ideas, methods, instructions or products referred to in the content. |
© 2023 by the authors. Licensee MDPI, Basel, Switzerland. This article is an open access article distributed under the terms and conditions of the Creative Commons Attribution (CC BY) license (https://creativecommons.org/licenses/by/4.0/).
Share and Cite
Wójtowicz, A.; Piekarczyk, J.; Wójtowicz, M.; Jasiewicz, J.; Królewicz, S.; Starzycka-Korbas, E. Classification of Plenodomus lingam and Plenodomus biglobosus in Co-Occurring Samples Using Reflectance Spectroscopy. Agriculture 2023, 13, 2228. https://doi.org/10.3390/agriculture13122228
Wójtowicz A, Piekarczyk J, Wójtowicz M, Jasiewicz J, Królewicz S, Starzycka-Korbas E. Classification of Plenodomus lingam and Plenodomus biglobosus in Co-Occurring Samples Using Reflectance Spectroscopy. Agriculture. 2023; 13(12):2228. https://doi.org/10.3390/agriculture13122228
Chicago/Turabian StyleWójtowicz, Andrzej, Jan Piekarczyk, Marek Wójtowicz, Jarosław Jasiewicz, Sławomir Królewicz, and Elżbieta Starzycka-Korbas. 2023. "Classification of Plenodomus lingam and Plenodomus biglobosus in Co-Occurring Samples Using Reflectance Spectroscopy" Agriculture 13, no. 12: 2228. https://doi.org/10.3390/agriculture13122228
APA StyleWójtowicz, A., Piekarczyk, J., Wójtowicz, M., Jasiewicz, J., Królewicz, S., & Starzycka-Korbas, E. (2023). Classification of Plenodomus lingam and Plenodomus biglobosus in Co-Occurring Samples Using Reflectance Spectroscopy. Agriculture, 13(12), 2228. https://doi.org/10.3390/agriculture13122228

